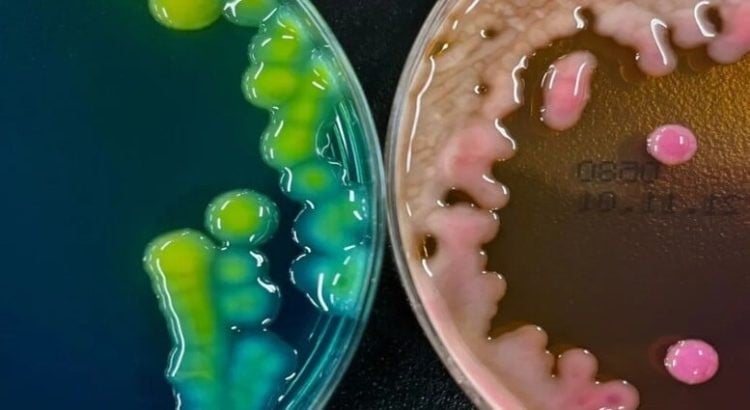

Ciudad de México, México.- La Organización Mundial de la Salud (OMS) ha designado recientemente a la variante XFG del SARS-CoV-2, conocida también como “Frankenstein” o Stratus, como una “variante bajo monitoreo” (VUM), debido a su creciente presencia a nivel mundial.
Aunque la variante ha mostrado una propagación acelerada en varias regiones, se ha determinado que el riesgo adicional que representa para la salud pública sigue siendo bajo. A continuación, te explicamos todo lo que necesitas saber sobre esta variante, cómo sigue funcionando la vacuna contra ella y qué hacer si experimentas síntomas.

¿Qué es la variante XFG?
La variante XFG es una variante recombinante de los linajes LF.7 y LP.8.1.2, que fue detectada por primera vez el 27 de enero de 2025. A lo largo de las últimas semanas, su presencia ha crecido considerablemente, especialmente en países del sudeste asiático, y ha mostrado una mayor evasión de anticuerpos, particularmente en ciertas posiciones de la proteína Spike, claves para la interacción con el sistema inmunológico.

Aunque los estudios preliminares indican que XFG tiene una reducción de 1.9 veces en la neutralización por anticuerpos en comparación con variantes anteriores, las vacunas aprobadas siguen siendo efectivas tanto para prevenir los síntomas como para evitar enfermedades graves. A pesar de su capacidad para evadir parcialmente los anticuerpos, la respuesta inmunitaria general sigue siendo robusta.
Aumento de casos en Asia y el mundo
El aumento de la variante XFG ha sido especialmente notable entre los meses de mayo y junio de 2025. En algunos países como Estados Unidos, India, España y el Reino Unido, se han registrado incrementos significativos de esta variante:
- Estados Unidos: Más del 30% de las secuencias genéticas analizadas corresponden a XFG.
- India: Más del 50% de las muestras genéticas son de XFG.
- España y Reino Unido: Alrededor del 30-42% de las secuencias genéticas.
India ha sido uno de los países más afectados, con XFG desplazando a otras variantes como la NB.1.8.1, lo que ha incrementado las hospitalizaciones en ciertas áreas del país. A pesar de esto, las autoridades sanitarias siguen monitoreando la variante con especial atención, ya que no se ha registrado un aumento significativo en la mortalidad.
Síntomas asociados con XFG

Aunque no se han registrado síntomas más graves que en otras variantes, los estudios preliminares indican que XFG podría estar asociada con algunos síntomas particulares, como:
- Dolor de garganta: De mayor frecuencia e intensidad que en otros linajes.
- Pérdida de audición: Un síntoma inusual en comparación con otras variantes del virus.
- Debilidad extrema y fatiga: Signos comunes de la infección.
- Boca seca y erupciones cutáneas: Otros síntomas que podrían ser característicos de XFG.
- Irritación generalizada: Es importante estar alerta ante cualquier malestar persistente.
Si experimentas estos síntomas, la OMS recomienda acudir al médico inmediatamente para una evaluación y diagnóstico preciso.
A pesar de las mutaciones presentadas por la variante XFG, las vacunas aprobadas siguen demostrando eficacia. El Grupo Técnico Asesor sobre Composición de Vacunas COVID-19 (TAG-CO-VAC) de la OMS recomienda mantener el uso de antígenos monovalentes como JN.1 o KP.2, ya que siguen siendo adecuados para ofrecer protección frente a esta variante.
También se ha considerado como alternativa el uso del antígeno monovalente LP.8.1, especialmente en países con alta circulación de XFG. Las autoridades sanitarias siguen recomendando la vacunación continua para mitigar el impacto de nuevas variantes.
¿Cómo puedes realizar la devolución de las vacunas o cambiar de dosis?
Aunque las vacunas siguen siendo seguras y efectivas, algunos usuarios pueden experimentar reacciones adversas. En caso de que experimentes efectos no deseados tras recibir una dosis de vacuna (como dolor en el lugar de aplicación, fiebre prolongada o reacciones alérgicas), puedes considerar la opción de contactar al centro de salud donde recibiste la dosis para consultar sobre los siguientes pasos:
- Consulta médica: Si experimentas síntomas inusuales después de la vacunación, acude a tu médico o a la clínica de vacunación para recibir una evaluación detallada.
- Solicitud de cambio de dosis: En algunos casos, los centros de salud pueden recomendar cambiar la vacuna administrada, ofreciendo otra opción que se ajuste mejor a tu perfil de salud. Los cambios generalmente dependen de la disponibilidad y las pautas nacionales de salud.
- Reembolsos o ajustes: Si recibiste la vacuna a través de un programa de salud pública o de una institución privada que ofrece devolución o cambio, puedes consultar las políticas locales para conocer si existe alguna opción de reembolso.
La OMS ha extendido hasta abril de 2026 las recomendaciones internacionales sobre el manejo del COVID-19, con un enfoque en la prevención y control de enfermedades. Aunque la variante XFG no ha aumentado el riesgo de mortalidad, sigue siendo importante realizar estudios de neutralización con muestras humanas y animales para detectar cambios en su comportamiento.